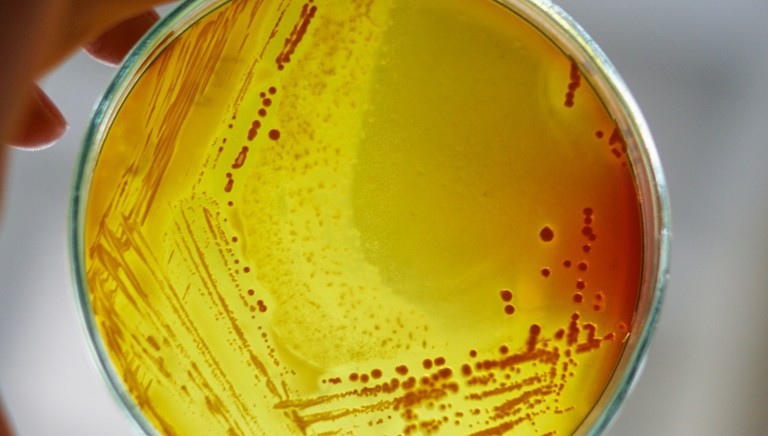
UK antibiotic subscription model key to supporting antibiotic investment

New approach to antibiotics good news for patients
The ABPI has responded to the NHS England and NHS Improvement announcement about a pioneering new approach for evaluating and reimbursing antimicrobials.
This lays the groundwork for rapidly establishing a permanent sustainable UK-wide solution for evaluating and reimbursing new antibiotics, which recognises the full value these treatments bring to patients, the NHS and society Dr Paul Catchpole
Speaking about the scheme, Dr Paul Catchpole, Value and Access Policy Director at the ABPI, said:
“Today’s announcement is excellent news for NHS patients with serious life-threatening infections and for incentivising the further development of new antibiotics to treat antimicrobial drug resistance.
"It lays the groundwork for rapidly establishing a permanent sustainable UK-wide solution for evaluating and reimbursing new antibiotics, which recognises the full value these treatments bring to patients, the NHS and society. This will allow the UK to play a full part, alongside the most developed economies to incentivise further global innovation.
"While approaches may be different across regions of the world, taken together they must act as an appropriate global incentive if we are to effectively tackle the growing challenge of antimicrobial drug resistance”.
- AMR
Last modified: 20 September 2023
Last reviewed: 20 September 2023